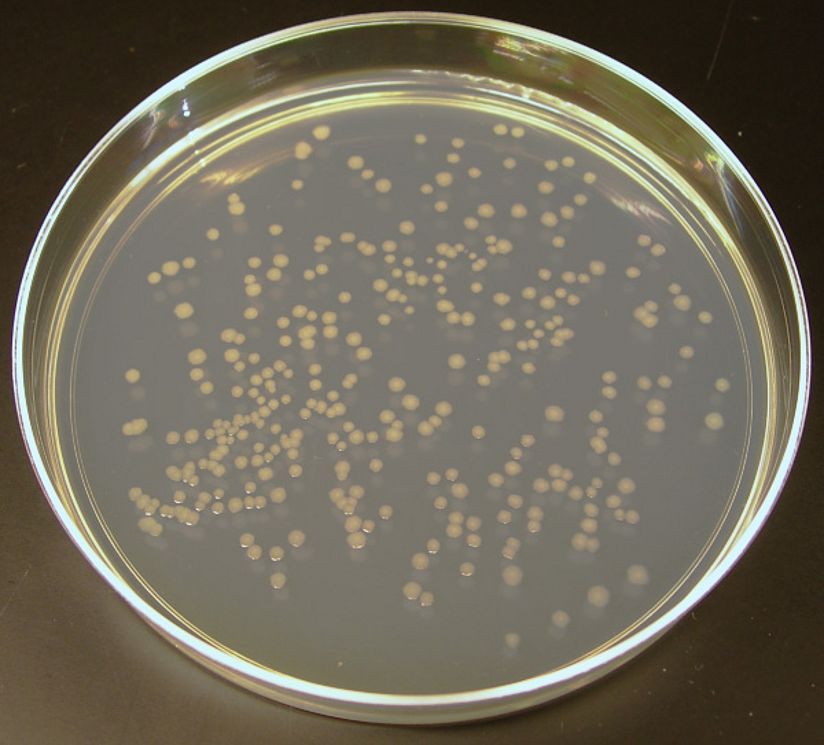
Auf einer Petrischale wachsen E.coli-Bakterien.

Christine Kolczewski
Christine Kolczewski leitet das Zentrum Neue Technologien (ZNT) und ist Kuratorin für Nano- und Biowissenschaften. Neben der Betreuung und Aktualisierung der Sammlung und Ausstellung zur Nano- und Biotechnologie gehört auch die Entwicklung und Planung von Veranstaltungen zum Thema Neue Technologien zu ihren Aufgaben.
Außerdem leitet sie die Abteilung Ausstellungsprojekte Sonderausstellungen und ist Ansprechpartnerin für alle großen und kleinen Sonderausstellungen auf der Museumsinsel.